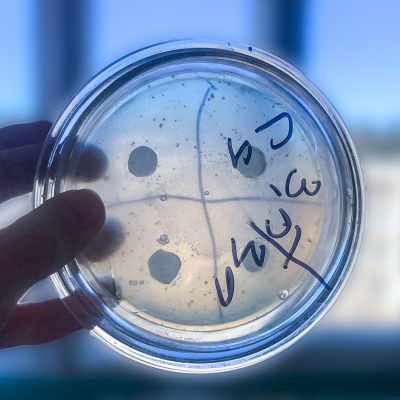

18 февраля отмечается праздник — день батарейки, посвящённый одному из открытий, сделанных в области физики и химии более 200 лет назад, но плодами которого сегодня пользуется каждый человек
экология


Ученые Пермского Политеха, Университета природных ресурсов и прикладных наук (Австрия) и компании JOMA Umwelt-Beratungsgesellschaft mbH (Германия) изучили, как быстро возвращается к прежнему состоянию окружающая среда на закрытых полигонах отходов
Сточные воды промышленных предприятий содержат токсичные органические соединения. Исследователи из ПНИПУ создают технологию, которая поможет улучшить эффективность их биологической очистки. Ученые выделили микроорганизмы, которые могут поглощать из стоков формальдегид

Студенты Лысьвенского филиала Пермского Политеха приняли участие во Всероссийском конкурсе творческих, проектных и исследовательских работ учащихся в области энерго- и ресурсосбережения «#ВместеЯрче». Проекты политехников заняли призовые места на региональном этапе мероприятия

В декабре в Пермском Политехе прошли защиты диссертаций аспирантов кафедры «Охрана окружающей среды». Сразу трем молодым ученым было присвоено звание кандидата технических наук

ПНИПУ поднялся на 13 позиций в мировом рейтинге экологической устойчивости университетов UI Greenmetric, заняв 140 строчку среди зарубежных вузов и 3 среди российских. Всего в список вошли 956 университетов из 80 стран

В России ежегодно образуется более 850 тыс. тонн отходов на основе резины. Ученые Пермского Политеха разработали способ переработки ненужных автомобильных шин, который поможет получить тепловую и электрическую энергию

Сегодня в 15:00 в Пермском Политехе состоится круглый стол «Климатически нейтральное природопользование». Мероприятие проводится в рамках V Международной научной конференции «От обращения с отходами к управлению ресурсами»

2 декабря в 15:00 в Пермском Политехе состоится круглый стол «Климатически нейтральное природопользование». Мероприятияе проводится в рамках V Международной научной конференции «От обращения с отходами к управлению ресурсами»

С 2 по 3 декабря в Пермском Политехе пройдет V Международная научная конференция «От обращения с отходами к управлению ресурсами». Заявки участников c докладом принимаются до 20 ноября, без доклада - до 30 ноября

